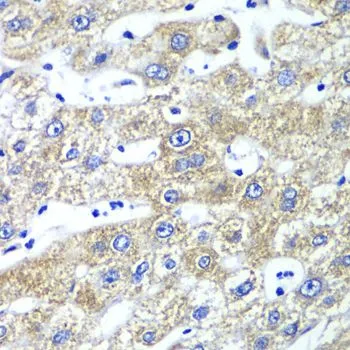

WB analysis of various sample lysates using GTX33449 QARS antibody. Dilution : 1:1000 Loading : 25microg per lane
QARS antibody
GTX33449
ApplicationsImmunoFluorescence, Western Blot, ImmunoCytoChemistry, ImmunoHistoChemistry, ImmunoHistoChemistry Paraffin
Product group Antibodies
TargetQARS1
Overview
- SupplierGeneTex
- Product NameQARS antibody
- Delivery Days Customer9
- Application Supplier NoteWB: 1:500 - 1:2000. ICC/IF: 1:50 - 1:100. IHC-P: 1:50 - 1:200. *Optimal dilutions/concentrations should be determined by the researcher.Not tested in other applications.
- ApplicationsImmunoFluorescence, Western Blot, ImmunoCytoChemistry, ImmunoHistoChemistry, ImmunoHistoChemistry Paraffin
- CertificationResearch Use Only
- ClonalityPolyclonal
- ConjugateUnconjugated
- Gene ID5859
- Target nameQARS1
- Target descriptionglutaminyl-tRNA synthetase 1
- Target synonymsGLNRS, MSCCA, PRO2195, QARS, glutamine--tRNA ligase, glutamine-tRNA synthetase
- HostRabbit
- IsotypeIgG
- Protein IDP47897
- Protein NameGlutamine--tRNA ligase
- Scientific DescriptionAminoacyl-tRNA synthetases catalyze the aminoacylation of tRNA by their cognate amino acid. Because of their central role in linking amino acids with nucleotide triplets contained in tRNAs, aminoacyl-tRNA synthetases are thought to be among the first proteins that appeared in evolution. In metazoans, 9 aminoacyl-tRNA synthetases specific for glutamine (gln), glutamic acid (glu), and 7 other amino acids are associated within a multienzyme complex. Although present in eukaryotes, glutaminyl-tRNA synthetase (QARS) is absent from many prokaryotes, mitochondria, and chloroplasts, in which Gln-tRNA(Gln) is formed by transamidation of the misacylated Glu-tRNA(Gln). Glutaminyl-tRNA synthetase belongs to the class-I aminoacyl-tRNA synthetase family. Alternative splicing results in multiple transcript variants. [provided by RefSeq, Jan 2013]
- Storage Instruction-20°C or -80°C,2°C to 8°C
- UNSPSC12352203